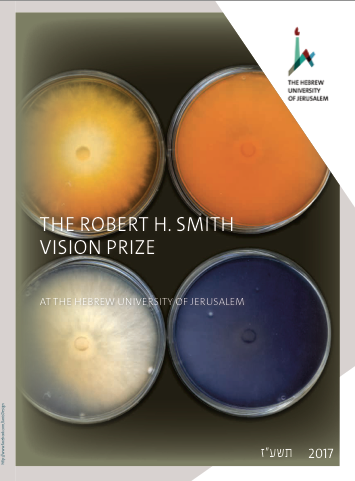
סמית

בטקס שהתקיים השבוע בירושלים הוענק לדריה פלדמן תלמידת לדוקטורט מהמחלקה למחלות צמחים ומיקרוביולוגיה , פרס החזון ע"ש רוברט ה. סמית.
בטקס שהתקיים השבוע בירושלים הוענק לדריה פלדמן תלמידת לדוקטורט מהמחלקה למחלות צמחים ומיקרוביולוגיה , פרס החזון ע"ש רוברט ה. סמית.
עבודת המחקר של דריה בהנחיית פרופ' עודד ירדן ופרופ' ויצחק הדר עוסקת באנזימים מפרקי ליגנין. הליגנין הוא מרכיב של דפנות תאי צמחים,
החזון הוא לנסות להפיק ביו-דלקים מפסולות חקלאיות זמינות זולות ובלתי מתכלות. התהליכים הנפוצים להפקת ביו-דלקים (אתנול) משתמשים ביבולים חקלאיים כגון תירס, אשר יכול לשמש כמזון ועל כן עלותו מייקרת את התהליך.הליגנין מצוי בחלקי צמח "עציים" ורק פרוקו למרכיבים פשוטים יאפשר להשתמש בו כמקור ליצירת דלק ביולוגי עבודת המחקר של דריה אמורה לאפשר פירוק יעיל של ליגנין הנמצא בפסולת חקלאיות.
העבודה ומתרכזת באנזימים מהפטריה Pleurotus ostreatus , שהיא פטריית מאכל המצטיינת ביכולת גבוהה של פירוק ליגנין. דריה השתמשה בחומר המדמה ליגנין והצליחה לגלות קבוצה של חלבונים קטנים המופרשים כדי לפרקו. באמצעות מניפולציות גנטיות דריה הוכיחה כי קבוצה זו משפיעה על פעילות האנזימים המפרקים את הליגנין עצמו. השאיפה היא להגיע ליכולת לבטא גנים בשמרים ובאמצעותם לייעל יצור דלק ממקורות
הדרך אכן ארוכה וכולנו יודעים שהמצאות גדולות מתחילות בצעדים קטנים. מי שמכיר את דריה יודע שהיא לא הולכת בדרך... היא רצה.
הדרך אכן ארוכה וכולנו יודעים שהמצאות גדולות מתחילות בצעדים קטנים. מי שמכיר את דריה יודע שהיא לא הולכת בדרך... היא רצה.
כל הכבוד!

